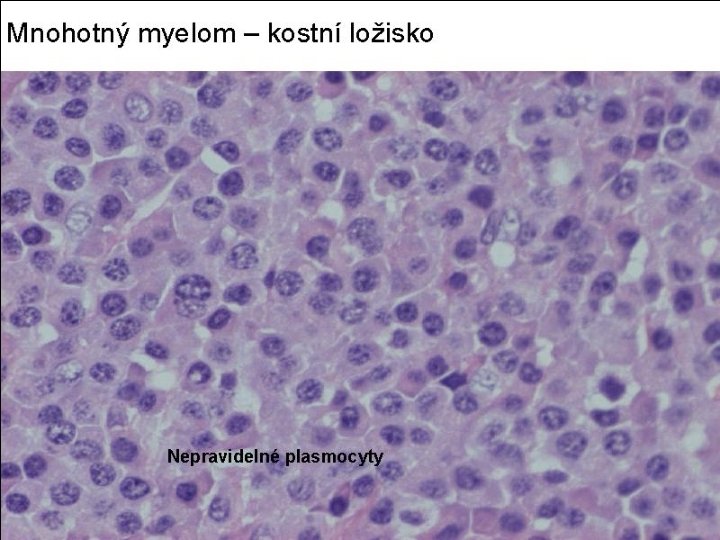

LYMPHADENITIS 2010 Lymfadenitidy Akutn nespecif lymfadenitis znt uzliny





































































- Slides: 69

LYMPHADENITIS 2010

Lymfadenitidy Akutní nespecif lymfadenitis: zánět uzliny drenující ložisko infekčního zánětu: zduřelé, zarudlé, v sinech polynukleáry Chronická nesp l-ad: (a) reaktivní folikulární hyperplazie, mitozy, fagocytující hc, různá velikost foll (B reakce), (b) parakortikální hyperplasie (T reakce), ale folikly a jejich centra atrofické, (c) sinusová histiocytóza, reakce na produkty malig TU, virové lfad, inf mononukl, Granulomatosní, toxoplasmová lymfadenitis (PiringerováKuchinková) Granulomatozně purulentní (cat scratch dis. ), Granulomat-nekrotisující, tularemie, pestis, anthrax, TBC Granulomatosní při sarkoidoze (bez kaseosních nekros)


















Klasifikace maligního lymfomu ML non Hodgkin • ML B řady • ML T řady ML Hodgkinův



B lymfocyty - ML

NHML, B a T Pre-B-lymfoblast: prekursorová B leukemie, prekurs B lymfoblastický lymfom (podobný = Burkittův ML s unif B lymfobl infiltr—Hc!). Naivní B (nestimul): CLL /SLL Po diferenciaci pre-B lymfocytů v naivní buňky a po jejich stimulaci antigenem se další vývoj děje dvěma směry: jednak v lymfatických foliklech, jednak v parakortexu: Stimulovaná B ve foliklu: folikulární lymfom: (a) z germinál center, (b) z plášt zony Difusní velkobuněčný lymfom (a) dif centroblastom, (b) imunoblastom, (c) anaplastický Postgerminální ML Difusní velkobuněčný lymfom, MALTOMy = ML marginální zony Stimulovaná B mimo folikl: imunoblastický ML/difusní velkobuněčný B lymfom, lymfoplasmocytoidní ML, Prekursorová T lymfoblastická leukemie, T lymfoblastický lymfom Periferní T cells: Mycosis fungoides, Sézaryho syndrom.


Non-Hodgkin ML B řady CLL-SCL: z naive B cells ~ malé lfc. Průběh chron, léčbou lze ještě zpomalit. Zpoč post jen uzliny, pak hepatosplenomeg, anémie, pak tr-cytopenie. V 5 -10% Richterův sy (→ Im-blastom, C-blastom) Imunocytom, z malých B lfc po stimulaci mimo folikl v parakortexu. Částečná difer k plasmocytům. Obs monotypický Ig (jeden tř, jeden lř). Při sekreci Ig vzn paraproteinémie a B-J bílkovina v moči. Možná amyloidóza. IC je morfol korelátem Waldenstr makroglob-aemie a heavy chain disease ~ Plasmocelul lymfom má všechny bb diferenc k pl-cytům, kostnímu plc myelomu Tricholeukémie z B bb, po stimulaci se difer folikulárním sm

Non-Hodgkin ML B řady Folikulární MLL –skup B lymfomů z bb lymf foliklů ML z bb zárodečných center (skr 2. 4): cc a cbl. Pokud cc je více než cbl, je ML benignější než cc<cbl. Mezi folikly je komprimovaný parakortex. Pravid rozlož stejné folikly, nízká mitot aktivita. Translok t(14, 18). BCL 2 gen = přeskupen, stimuluje tvorbu BCL 2 proteinu (lze dg IHC) Lymfom plášťové zony (skr 2. 5) z bb pláště, v centru jsou zpočátku zachov nenád zár centra. Translokace t(11, 14) s přeskupením a aktivací BCL-1 genu (Cyclin D-1)

Non-Hodgkin ML B řady Difusní velkobuněčný lymfom, agresivní, je buď difusní centroblastom (difusní varianta z centroblastů zárodečných center), (bb 4 x větší neč lfc se 2 jadérky) nebo imunoblastom (ještě větší bb, 1 basof velké jad) v 80% z B bb, ve 20% z T-Cbl či Ibl. Lymfoblastický ML z malých B bb = Burrkittův. Rovníková Afrika, post děti, oblast dolní čelisti, mimo Afriku břišní orgány, ledv a ovaria; v 75% transl t(8, 14), méně t(8, 22) nebo t(2, 8). Histol starry sky. Etiol EBV ?























Non-Hodgkin, T řada T h y m u s: T lymfocyty se postupně diferencují včetně povrchových CD antigenů (CD 4 -, CD 8 -) → (CD 4+, CD 8+) (CD 4+CD 8 -): T- helpery (CD 8+CD 4 -): T-cytotox Zralé T lfc cestují do periferie (uzliny, kůže) Mycosis fungoides, periferní CD 4+ T cells v koriu, cerebriformní jádro, epidermotropismus. Tři stadia: , premykotické, mykotické/tumorosní a generalizace. Sézaryho sy je leukemická varianta m. f. Prekursorový T lymfoblastický lymfom z (CD 4+, CD 8+) nebo z (CD 4 -, CD 8 -) lymfocytů. Anaplastický velkobuněčný T lymfom: je z Ki-1, CD 30+ bb, velké prekursorové, blastické až epiteloidní buňky,